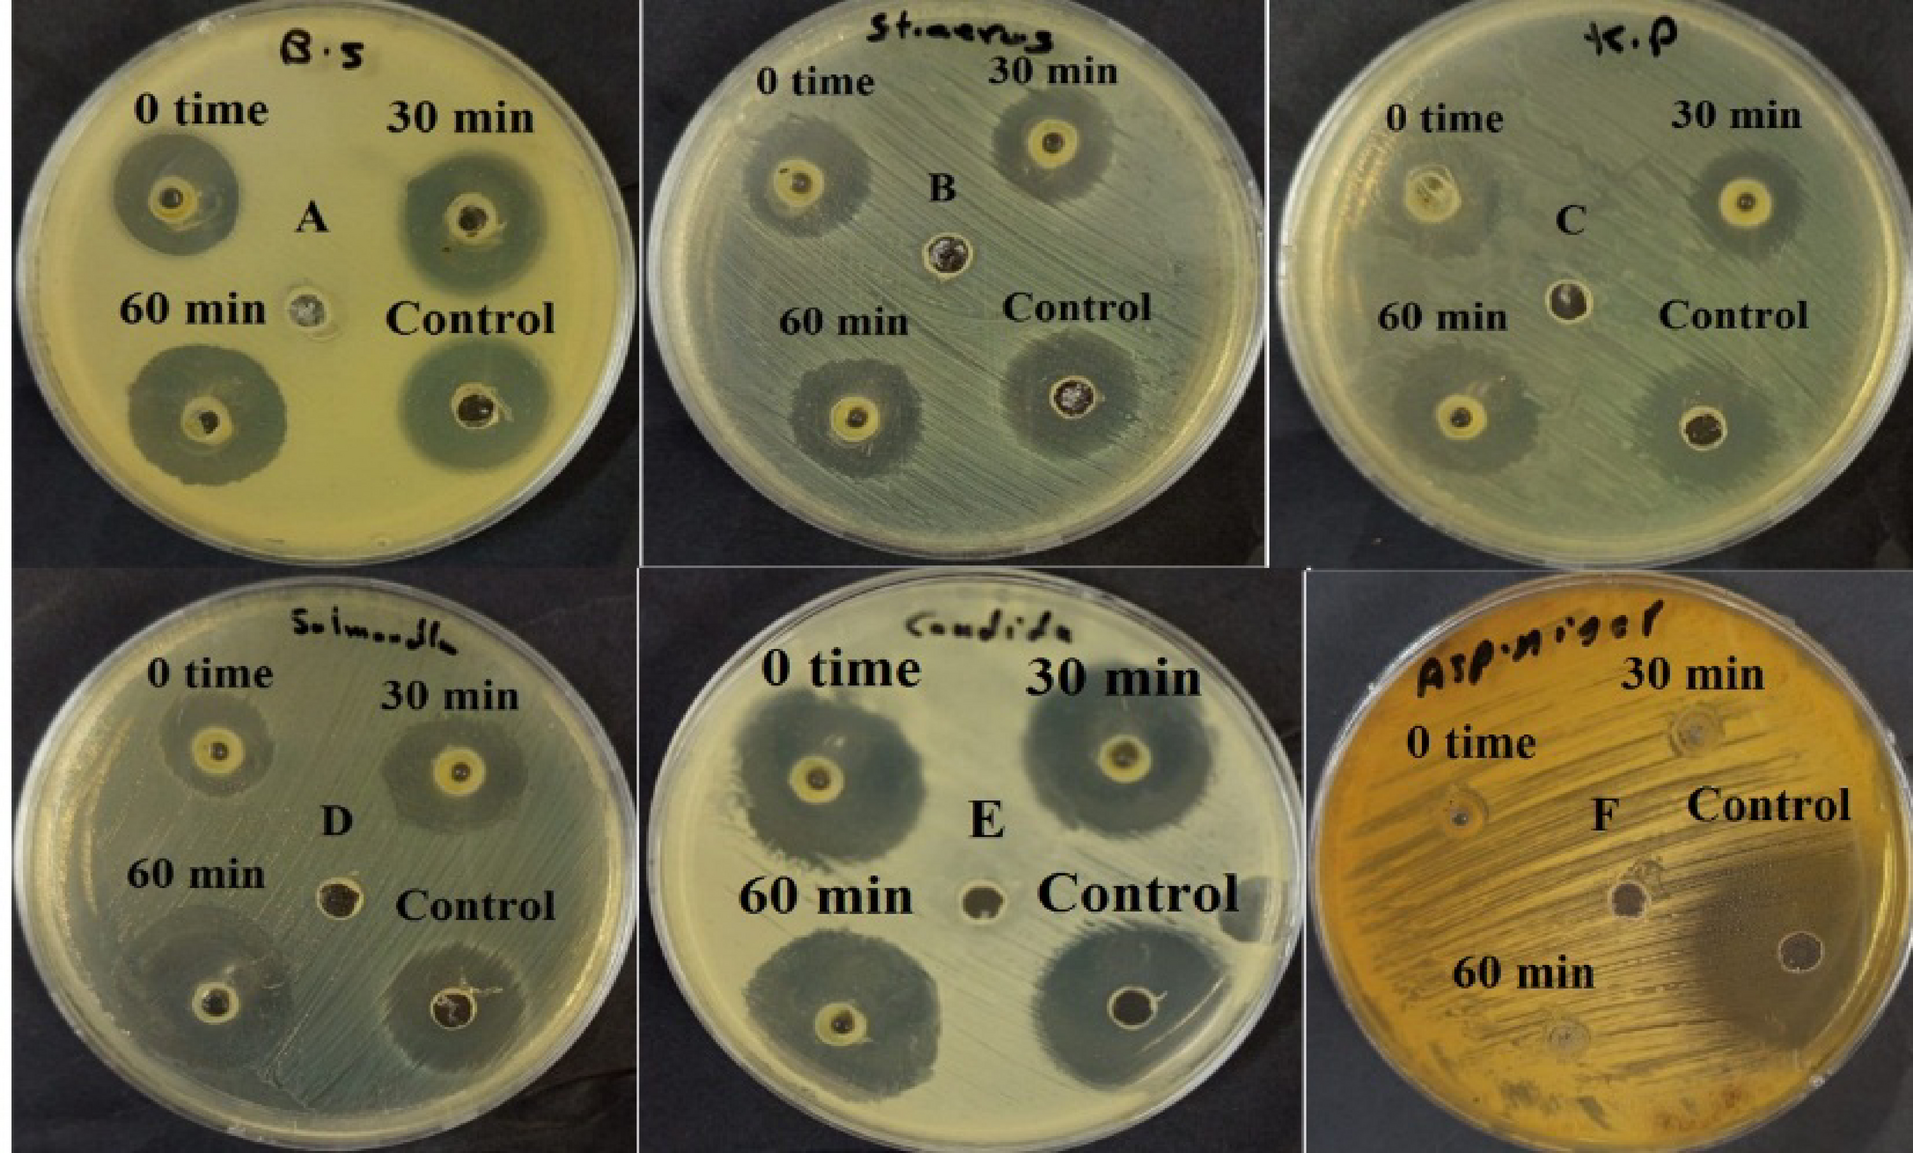
Fig. 2

Fig. 2
From: UV-C irradiation enhances the antimicrobial and Anti-Inflammatory bioactivity of ginseng oil
Antimicrobial activity of GOE at different time intervals against: (A) B. subtilis, (B) S. aureus, (C) K. pneumoniae, (D) S. typhi, (E) C. albicans, and (F) A. niger.
